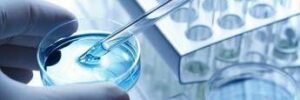

(Adnkronos) – I progressi scientifici e le terapie innovative, che stanno trasformando le opportunità di trattamento e le prospettive di cura in ematologia, hanno bisogno di una riorganizzazione del sistema sanitario. Proprio su questo tema si è svolto oggi presso la Giunta regionale della Lombardia l'evento istituzionale 'Ematologia in Regione Lombardia – Strategie regionali per l'innovazione', promosso da Johnson & Johnson, con l'obiettivo di creare un'occasione di confronto tra tutti gli attori del sistema salute e individuare proposte in ambito organizzativo e gestionale per la presa in carico del paziente ematologico in tutta le regione. Nel dettaglio, dal confronto tra le istituzioni regionali, i clinici e le associazioni del Terzo settore, per garantire l'accesso all'innovazione terapeutica, accelerare la diagnosi e migliorare la presa in carico dei pazienti ematologici – informa una nota – emergono queste necessità: 1) Riorganizzare in maniera efficiente le risorse economiche disponibili per garantire a livello regionale l'accesso all'innovazione a tutti i pazienti ematologici che ne hanno bisogno, implementando una nuova governance condivisa per tipologia di esami, verifica degli esiti e dell'efficacia, capace di rendere uniforme sul territorio l'appropriatezza degli esiti e della gestione delle patologie nel loro complesso; 2) Adeguare il modello gestionale-organizzativo di presa in carico dei pazienti sulla base delle nuove esigenze cliniche e dei nuovi trattamenti disponibili per rispondere tempestivamente ai bisogni di salute in ematologia; 3) Aumentare l'organico amministrativo al fine di gestire gli aspetti burocratici legati alla presa in carico del paziente affinché gli specialisti possano dedicare più tempo alla pratica clinica, come da proposta già avanzata dalla Commissione III Sanità. Ancora: 4) Integrare la Rete ematologica lombarda con la partecipazione delle associazioni di pazienti e delle istituzioni regionali competenti in materia, favorendo la costituzione di un tavolo programmatico che, a livello regionale, traduca in provvedimenti operativi le istanze raccolte. Riconoscere, allo stesso tempo, il ruolo cruciale del terzo settore e delle associazioni di pazienti in ambito ematologico nel garantire il benessere complessivo del paziente, con un loro coinvolgimento attivo e istituzionalizzato nei tavoli decisionali a livello regionale. Infine: 5) Proporre un pilota che, in linea con le Linee guida Agenas e il Protocollo regionale, ripensi l'assistenza in termini di territorializzazione delle cure onco-ematologiche e di una maggiore valorizzazione delle Case di comunità. L'ematologia – ricordano gli esperti – rappresenta da sempre l'avamposto dell'innovazione terapeutica in ambito oncologico, dove nel corso degli ultimi 10 anni sono state introdotte nuove opzioni terapeutiche in grado di prolungare e migliorare la vita dei pazienti. Un caso particolare è rappresentato dal mieloma multiplo, la seconda forma più comune tra i tumori del sangue, con un'incidenza progressivamente in aumento, tanto che nel nostro Paese si contano ogni anno quasi 6mila nuovi casi – circa 800 solo in Lombardia – e dove la sopravvivenza dopo la diagnosi è significativamente aumentata passando da 2 a oltre 7 anni. La spinta all'innovazione data dalla necessità di adottare terapie sempre più personalizzate ed efficaci rappresenta una sfida per tutti gli attori del sistema salute, dai clinici che somministrano queste terapie alle associazioni che supportano i pazienti nel loro percorso di cura, dalle aziende che fanno ricerca alle istituzioni. Per garantire l'accesso alle migliori terapie disponibili e al contempo la sostenibilità del sistema sanitario regionale, è necessario ripensare all'ecosistema a livello regionale in termini di gestione e organizzazione. "Quando parliamo di innovazione in ambito sanitario, sono 3 le parole chiave da tenere a mente: equità, sostenibilità e adeguatezza rispetto al bene più prezioso che abbiamo nel nostro Paese e nella nostra Regione, il nostro sistema sanitario – afferma Marco Alparone, vicepresidente e assessore al Bilancio e finanza, Regione Lombardia – Se da un lato questo comporta già il valore dell'equità, dall'altro, di fronte alla spinta all'innovazione, va implementato nella sostenibilità. Questa è la sfida che dobbiamo affrontare insieme tra tutti i protagonisti del mondo della salute e della sanità, a partire da clinici, istituzioni, associazioni dei pazienti, loro familiari, cambiando in maniera radicale i modelli organizzativi. L'obiettivo – precisa – è quello di garantire uniformità delle cure, consentendo ai pazienti le terapie migliori su tutto il territorio regionale, in maniera omogenea, senza differenze. Per tali motivi, incontri come questo di oggi incontri rappresentano opportunità di confronto e dialogo essenziali, su tematiche molto delicate, come l’ematologia e il mieloma multiplo". "Per migliorare la presa in carico delle persone con mieloma multiplo – sottolinea Francesco Passamonti, direttore Sc Ematologia, Policlinico di Milano e professore ordinario di Ematologia, Dipartimento di Oncologia e Onco-Ematologia, università degli Studi di Milano – è necessario promuovere un cambiamento di alcuni dei modelli organizzativi, così da definire percorsi di cura che assicurino un accesso precoce alla diagnosi e ai trattamenti. In tal senso, è necessario che l'assistenza sia più territoriale, riducendo così il carico degli ospedali. Questo – chiarisce – è ciò che accade ad esempio nel modello Hub & Spoke, dove nei centri Hub vengono indirizzati i pazienti con maggiore complessità terapeutica, mentre chi non richiede più cure specialistiche può essere seguito in quelli Spoke. Nel nostro territorio, un importante supporto può essere dato dalle Case di comunità, laddove venga garantito però un alto livello di competenza specialistica". Aggiunge Roberto Cairoli, direttore Sc Ematologia, Asst Gom Niguarda Milano e professore associato di Malattie del sangue, Dipartimento di Medicina e chirurgia, università degli Studi di Milano-Bicocca: "E' fondamentale che vi sia una un'armonizzazione a livello regionale delle strategie da utilizzare, a partire da esami, approfondimenti e verifiche degli esiti in modo tale da gestire la malattia ematologica nel suo complesso. Ma per fare ciò, è altrettanto fondamentale agire come una vera e propria rete con il fine ultimo di garantire i 3 principi chiave dell'equità all'accesso: sostenibilità, prossimità e appropriatezza. Con una maggiore integrazione, la Rete ematologica lombarda può contribuire a introdurre elementi di monitoraggio per bilanciare le necessità di accesso, appropriatezza e utilizzo strategico delle risorse. Tutto ciò – avverte – passa dal coinvolgimento di tutte le figure coinvolte nel percorso di presa in carico e cura del paziente, a partire dalla costruzione di tavoli programmatici che, a livello regionale, possano tradurre in provvedimenti operativi ed efficaci i bisogni portati avanti dai professionisti sanitari e dai pazienti". "In linea con la prospettiva nazionale – osserva Davide Petruzzelli, presidente La Lampada di Aladino Ets – risulta fondamentale istituzionalizzare il ruolo delle associazioni di pazienti nei processi decisionali del sistema salute. Questo tipo di partecipazione è attualmente più consolidata in oncologia; è importante però lavorare nella stessa direzione anche in ambito ematologico, dove le differenze nell'accesso alle cure sono purtroppo sempre più presenti, anche nella nostra regione. Lo scopo è puntare alla presa in carico complessiva particolarmente quando si tratta di persone anziane, oltre ai bisogni puramente clinici. Per questo è necessaria la massima collaborazione tra i diversi professionisti, ma anche tra ospedale e territorio". Commenta Monica Gibellini, direttore Government Affairs, Policy & Patient Engagement Johnson & Johnson Innovative Medicine Italia: "Come Johnson & Johnson da sempre siamo protagonisti dell'innovazione in tutte le sue forme, non solo attraverso la ricerca scientifica, ma anche promuovendo iniziative che possano migliorare i modelli gestionali di presa in carico delle persone con tumori ematologici, come il mieloma multiplo. Siamo convinti che attraverso momenti di confronto come questo, che ha visto coinvolti tutti i principali rappresentanti del sistema salute, stiamo procedendo nella direzione giusta per affrontare la sfida di un sistema che consideri sempre di più la spesa farmaceutica come un investimento a cui destinare le risorse necessarie, così da rispondere sempre meglio ai bisogni di cura dei pazienti per una loro corretta e tempestiva presa in carico". —salutewebinfo@adnkronos.com (Web Info)
📲 Ricevi gratis le notizie di Montagne & Paesi sul tuo telefonino!
Iscriviti al nostro canale WhatsApp ufficiale per restare sempre aggiornato su notizie e curiosità dalle valli.
📢 Seguici anche su Telegram!
Unisciti al canale Telegram di Montagne & Paesi per ricevere tutte le news in tempo reale.